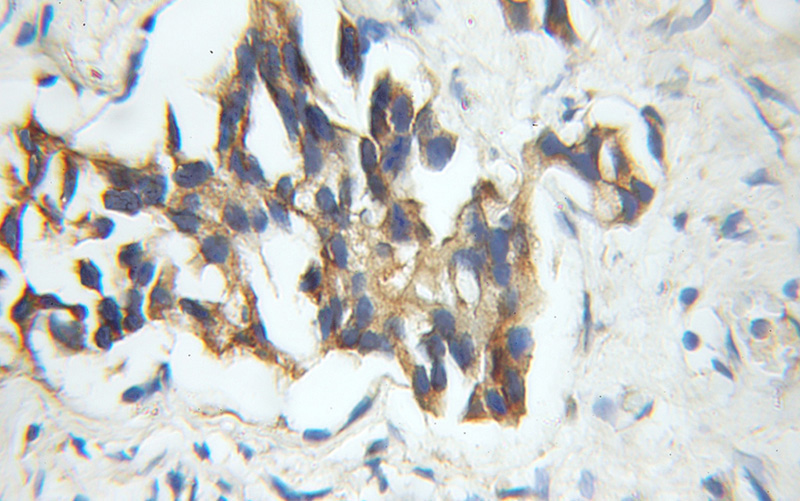

-
Product Name
VPRBP antibody
- Documents
-
Description
VPRBP Rabbit Polyclonal antibody. Positive IHC detected in human prostate cancer tissue. Positive FC detected in HeLa cells. Positive WB detected in HeLa cells, HEK-293 cells, K-562 cells, mouse testis tissue, PC-3 cells. Positive IP detected in HeLa cells. Observed molecular weight by Western-blot: 169 kDa
-
Tested applications
ELISA, WB, IHC, IP, FC
-
Species reactivity
Human,Mouse,Rat; other species not tested.
-
Alternative names
DCAF1 antibody; HIV 1 Vpr binding protein antibody; KIAA0800 antibody; Protein VPRBP antibody; RIP antibody; Vpr (HIV 1) binding protein antibody; Vpr interacting protein antibody; VPRBP antibody
-
Isotype
Rabbit IgG
-
Preparation
This antibody was obtained by immunization of VPRBP recombinant protein (Accession Number: BC022792). Purification method: Antigen affinity purified.
-
Clonality
Polyclonal
-
Formulation
PBS with 0.1% sodium azide and 50% glycerol pH 7.3.
-
Storage instructions
Store at -20℃. DO NOT ALIQUOT
-
Applications
Recommended Dilution:
WB: 1:500-1:5000
IP: 1:500-1:5000
IHC: 1:20-1:200
-
Validations

HeLa cells were subjected to SDS PAGE followed by western blot with Catalog No:116768(VPRBP antibody) at dilution of 1:500

IP Result of anti-VPRBP (IP:Catalog No:116768, 3ug; Detection:Catalog No:116768 1:1000) with HeLa cells lysate 3800ug.
Immunohistochemical of paraffin-embedded human prostate cancer using Catalog No:116768(VPRBP antibody) at dilution of 1:50 (under 10x lens)

1X10^6 HeLa cells were stained with 0.2ug VPRBP antibody (Catalog No:116768, red) and control antibody (blue). Fixed with 4% PFA blocked with 3% BSA (30 min). Alexa Fluor 488-congugated AffiniPure Goat Anti-Rabbit IgG(H+L) with dilution 1:1000.
-
Background
VprBP was first identified as a protein that can interact with HIV-1 viral protein R (PMID: 11223251). It is a component of the CUL4A-RBX1-DDB1-VprBP/DCAF1 E3 ubiquitin-protein ligase complex that could interact with HIV-1 virus Vpr protein and HIV-2 virus Vpx protein (PMID: 18332868; 17314515; 18606781). VprBP is a 1,507-amino acid protein that contains conserved domains, including YXXY repeats, the Lis homology motif, and WD40 repeats. Through binding to Vpr, VprBP allows Vpr to modulate the catalytic activity of the CUL4-DDB1 complex, which in turn leads to the induction of G2 phase arrest in the virus-infected cells (PMID: 17630831). Recently it has been reported that VprBP is able to regulate the p53-induced transcription and apoptotic pathway (PMID: 22184063).
-
References
- de Silva S, Planelles V, Wu L. Differential effects of Vpr on single-cycle and spreading HIV-1 infections in CD4+ T-cells and dendritic cells. PloS one. 7(5):e35385. 2012.
- Wang BS, Liu YZ, Yang Y. Autophagy negatively regulates cancer cell proliferation via selectively targeting VPRBP. Clinical science (London, England : 1979). 124(3):203-14. 2013.
- Kyei GB, Cheng X, Ramani R, Ratner L. Cyclin L2 is a critical HIV dependency factor in macrophages that controls SAMHD1 abundance. Cell host & microbe. 17(1):98-106. 2015.
- Nakagawa T, Lv L, Nakagawa M. CRL4(VprBP) E3 ligase promotes monoubiquitylation and chromatin binding of TET dioxygenases. Molecular cell. 57(2):247-60. 2015.
- Jáuregui P, Logue EC, Schultz ML, Fung S, Landau NR. Degradation of SAMHD1 by Vpx Is Independent of Uncoating. Journal of virology. 89(10):5701-13. 2015.
- Collins DR, Lubow J, Lukic Z, Mashiba M, Collins KL. Vpr Promotes Macrophage-Dependent HIV-1 Infection of CD4+ T Lymphocytes. PLoS pathogens. 11(7):e1005054. 2015.
- Kim K, Lee B, Kim J. Linker Histone H1.2 cooperates with Cul4A and PAF1 to drive H4K31 ubiquitylation-mediated transactivation. Cell reports. 5(6):1690-703. 2013.
- Kim K, Heo K, Choi J. Vpr-binding protein antagonizes p53-mediated transcription via direct interaction with H3 tail. Molecular and cellular biology. 32(4):783-96. 2012.
Related Products / Services
Please note: All products are "FOR RESEARCH USE ONLY AND ARE NOT INTENDED FOR DIAGNOSTIC OR THERAPEUTIC USE"
